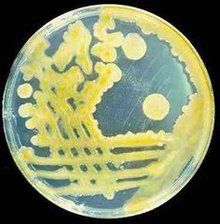
甲基單胞菌科

正文
細菌的 1科。本科細菌為單細胞,桿狀或球狀;以單極毛運動或不運動;以二分分裂法繁殖。能利用甲烷、甲醇等含甲基的單碳化合物為碳源和能源,所以又稱甲烷氧化菌。本科細菌分布較廣,在含甲烷的自然基質中都可能有甲烷氧化菌生長。它們大多與一些不能氧化甲烷的異養菌共生或伴生,分離、純化和保留純種極為困難。它們都是化能有機營養菌,對無機營養無嚴格要求,有的種能利用空氣中的分子氮作氮源。微量的胺基酸、多肽等有機物質能抑制其生長,甚至有的甲烷氧化菌也受極微量甲醇的抑制。嚴格好氧,以氧分子作為電子受體,將甲烷漸次氧化成醇、醛、酸、直到二氧化碳,通過單磷酸核糖途徑或絲氨酸途徑獲取能量。在氧化甲烷時能將其他一些不能同化的烴類或其衍生物進行協同氧化,如將己烷氧化成乙醇、將丙烯氧化成環氧丙烷等。《伯傑氏鑑定細菌學手冊》第 8版中描述了兩個屬:甲基單胞菌屬與甲基球菌屬,共4個種。近年來先後報導20多株利用甲烷的專性細菌,並建立了甲基彎菌與甲基囊菌兩個新屬。中國報導了 3種用甲烷作為唯一碳源與能源、以多孢子進行繁殖的甲烷氧化菌,因其繁殖特徵不同於已知的各類細菌,從而建立一個獨立的多孢子菌屬。此外,不利用甲烷而利用甲胺或甲醇與其他含碳物質的兼性甲基營養菌則更多。
甲烷氧化菌對於製取某些用化學手段難以得到的化工原料有重要意義。用甲烷氧化菌雖可製取無毒性的單細胞蛋白,但因工藝複雜與成本較高而未能投產。
配圖
甲基單胞菌科
甲基單胞菌科
